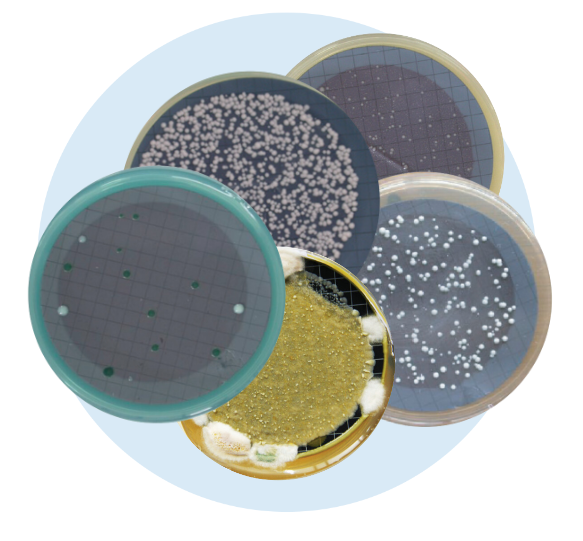
Milieux brettanomyces boîte diamètre 55 mm (x10)

Caractéristiques
Type : Milieu gélosé sélectif & spécifique - prêt à l’emploi
Milieux brettanomyces boîte diamètre 55 mm (x10)
Ref. produit ECLMIL-BRETT
Utilisés pour l’identification et le dénombrement, ces milieux sont conformes à la résolution OIV-OENO 206/2010.OENO 206/2010.
48,28 € HT
Pour connaître la disponibilité, merci de vous connecter.
Produits associés

Membranes stérile MCE noire 0.45 µ, quad, 47 mm, en boîte ( X 100 )
FILTRATECH
Ref. FTTMF047ME045BGSC
51,11 € HT

Membranes stérile unitaire MCE blanche 0.45 µ, quadrillage vert, 47 mm, en boîte ( x 100 )
FILTRATECH
Ref. FTTMF047ME045WGSC
33,57 € HT











